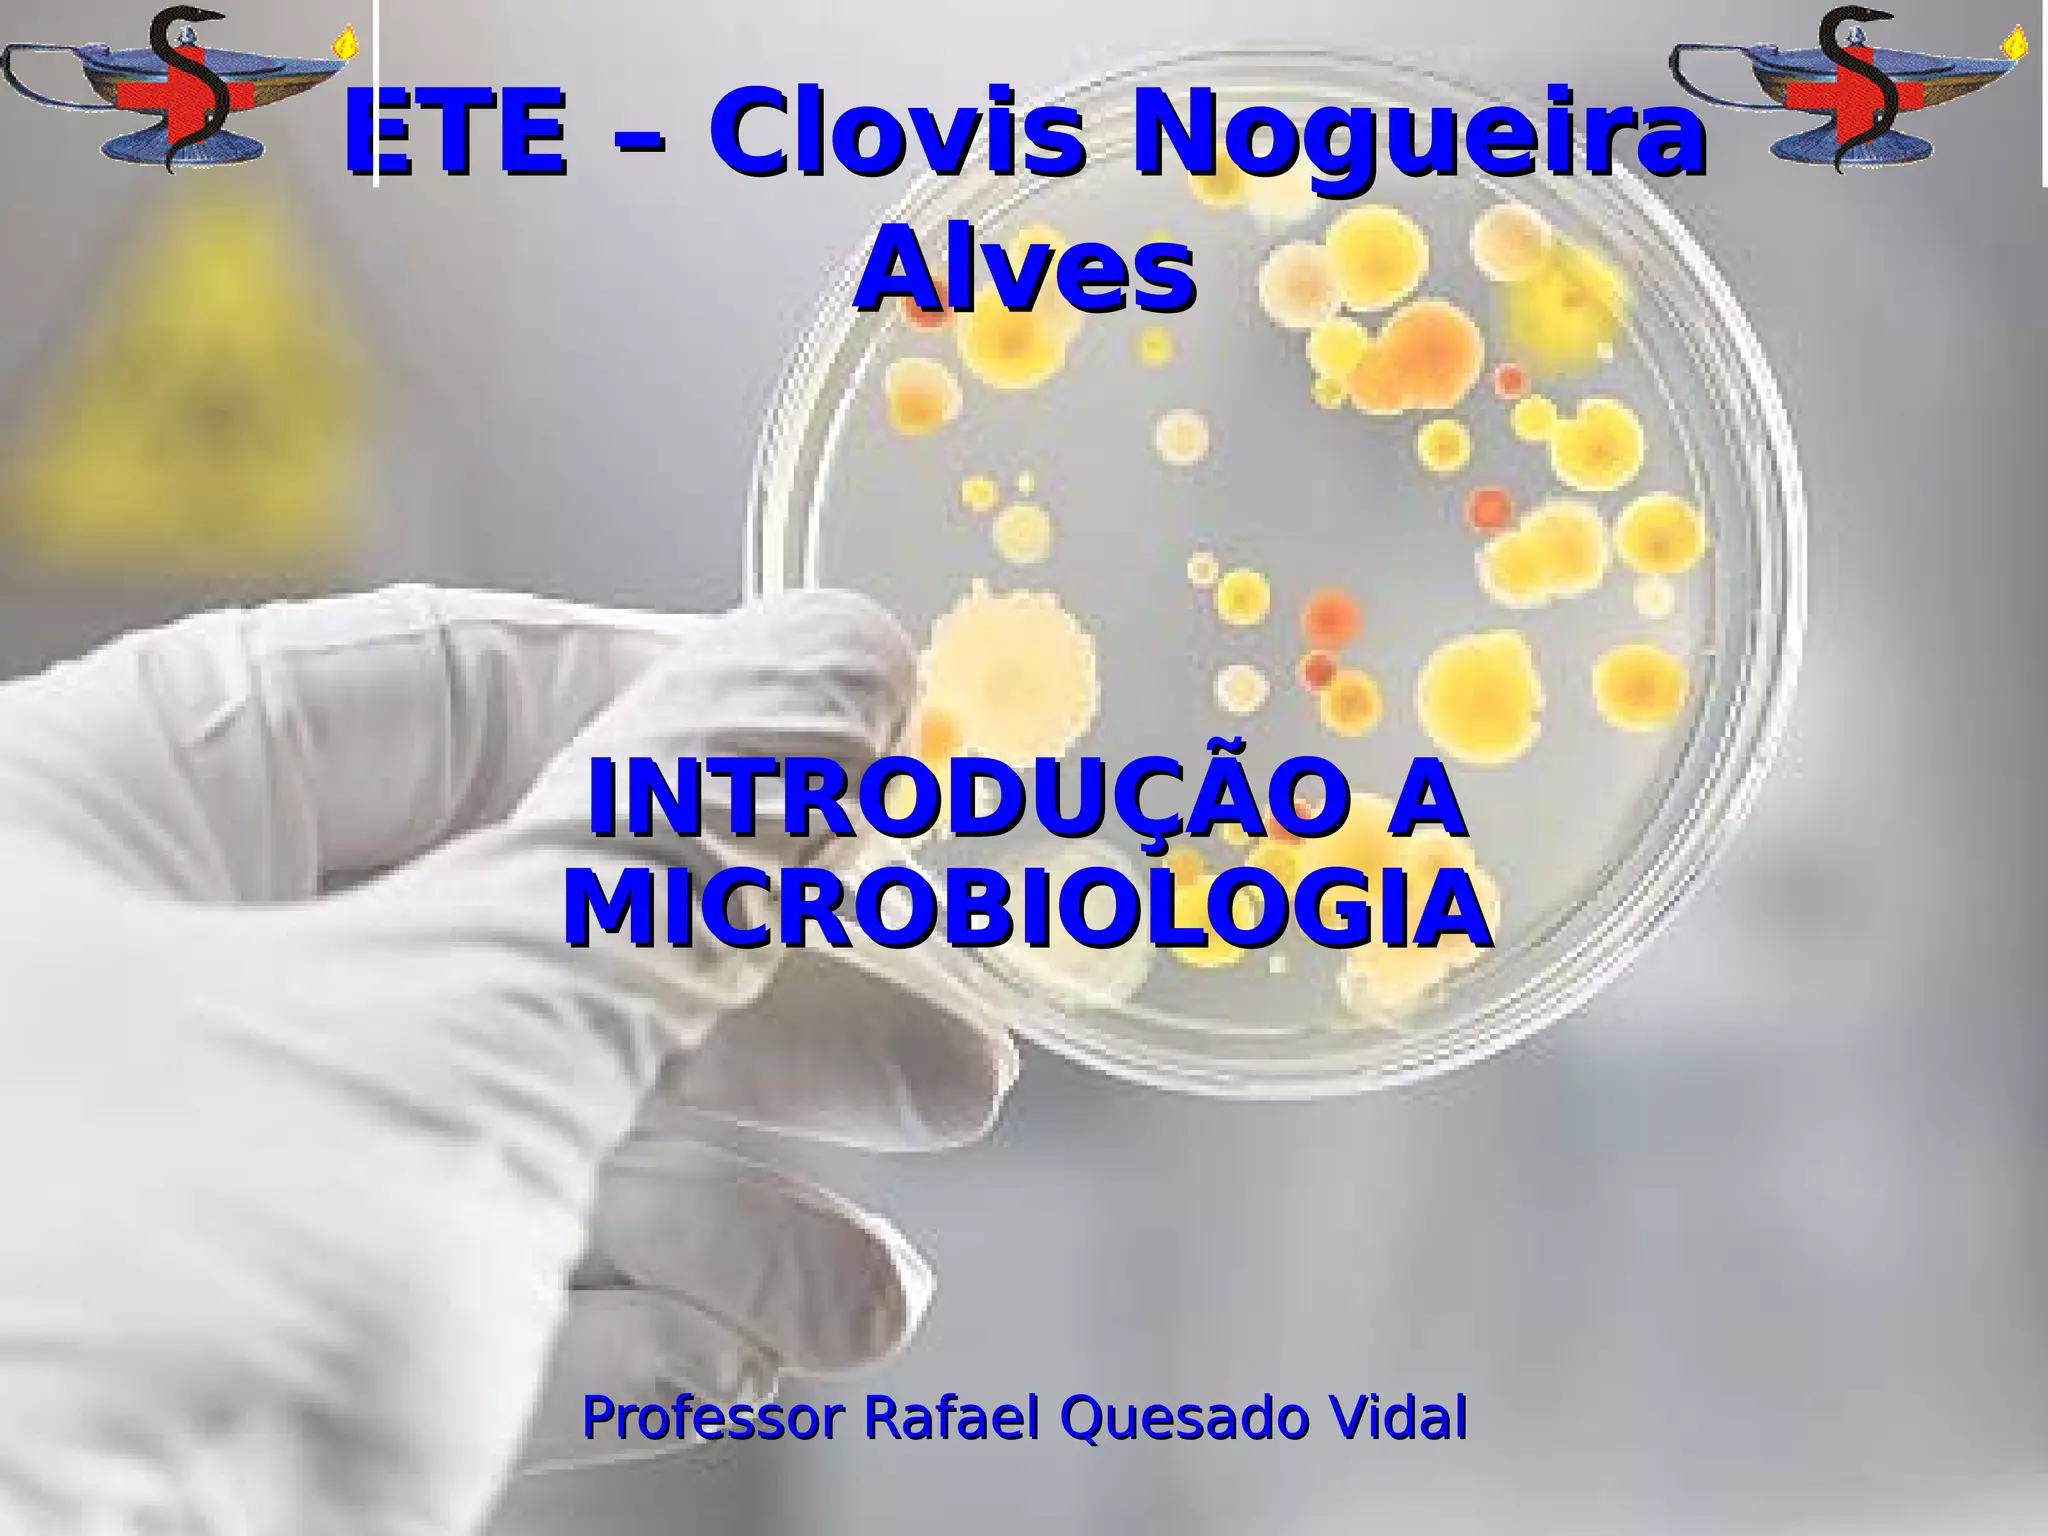

O documento introduz os conceitos básicos de microbiologia, incluindo a definição da área, a importância histórica e aplicações. Aborda as principais teorias de classificação de seres vivos, destacando a teoria de Whittaker que divide em cinco reinos: Monera, Protista, Fungi, Plantae e Animalia. Explana também as diferenças entre células procariotas e eucariotas.